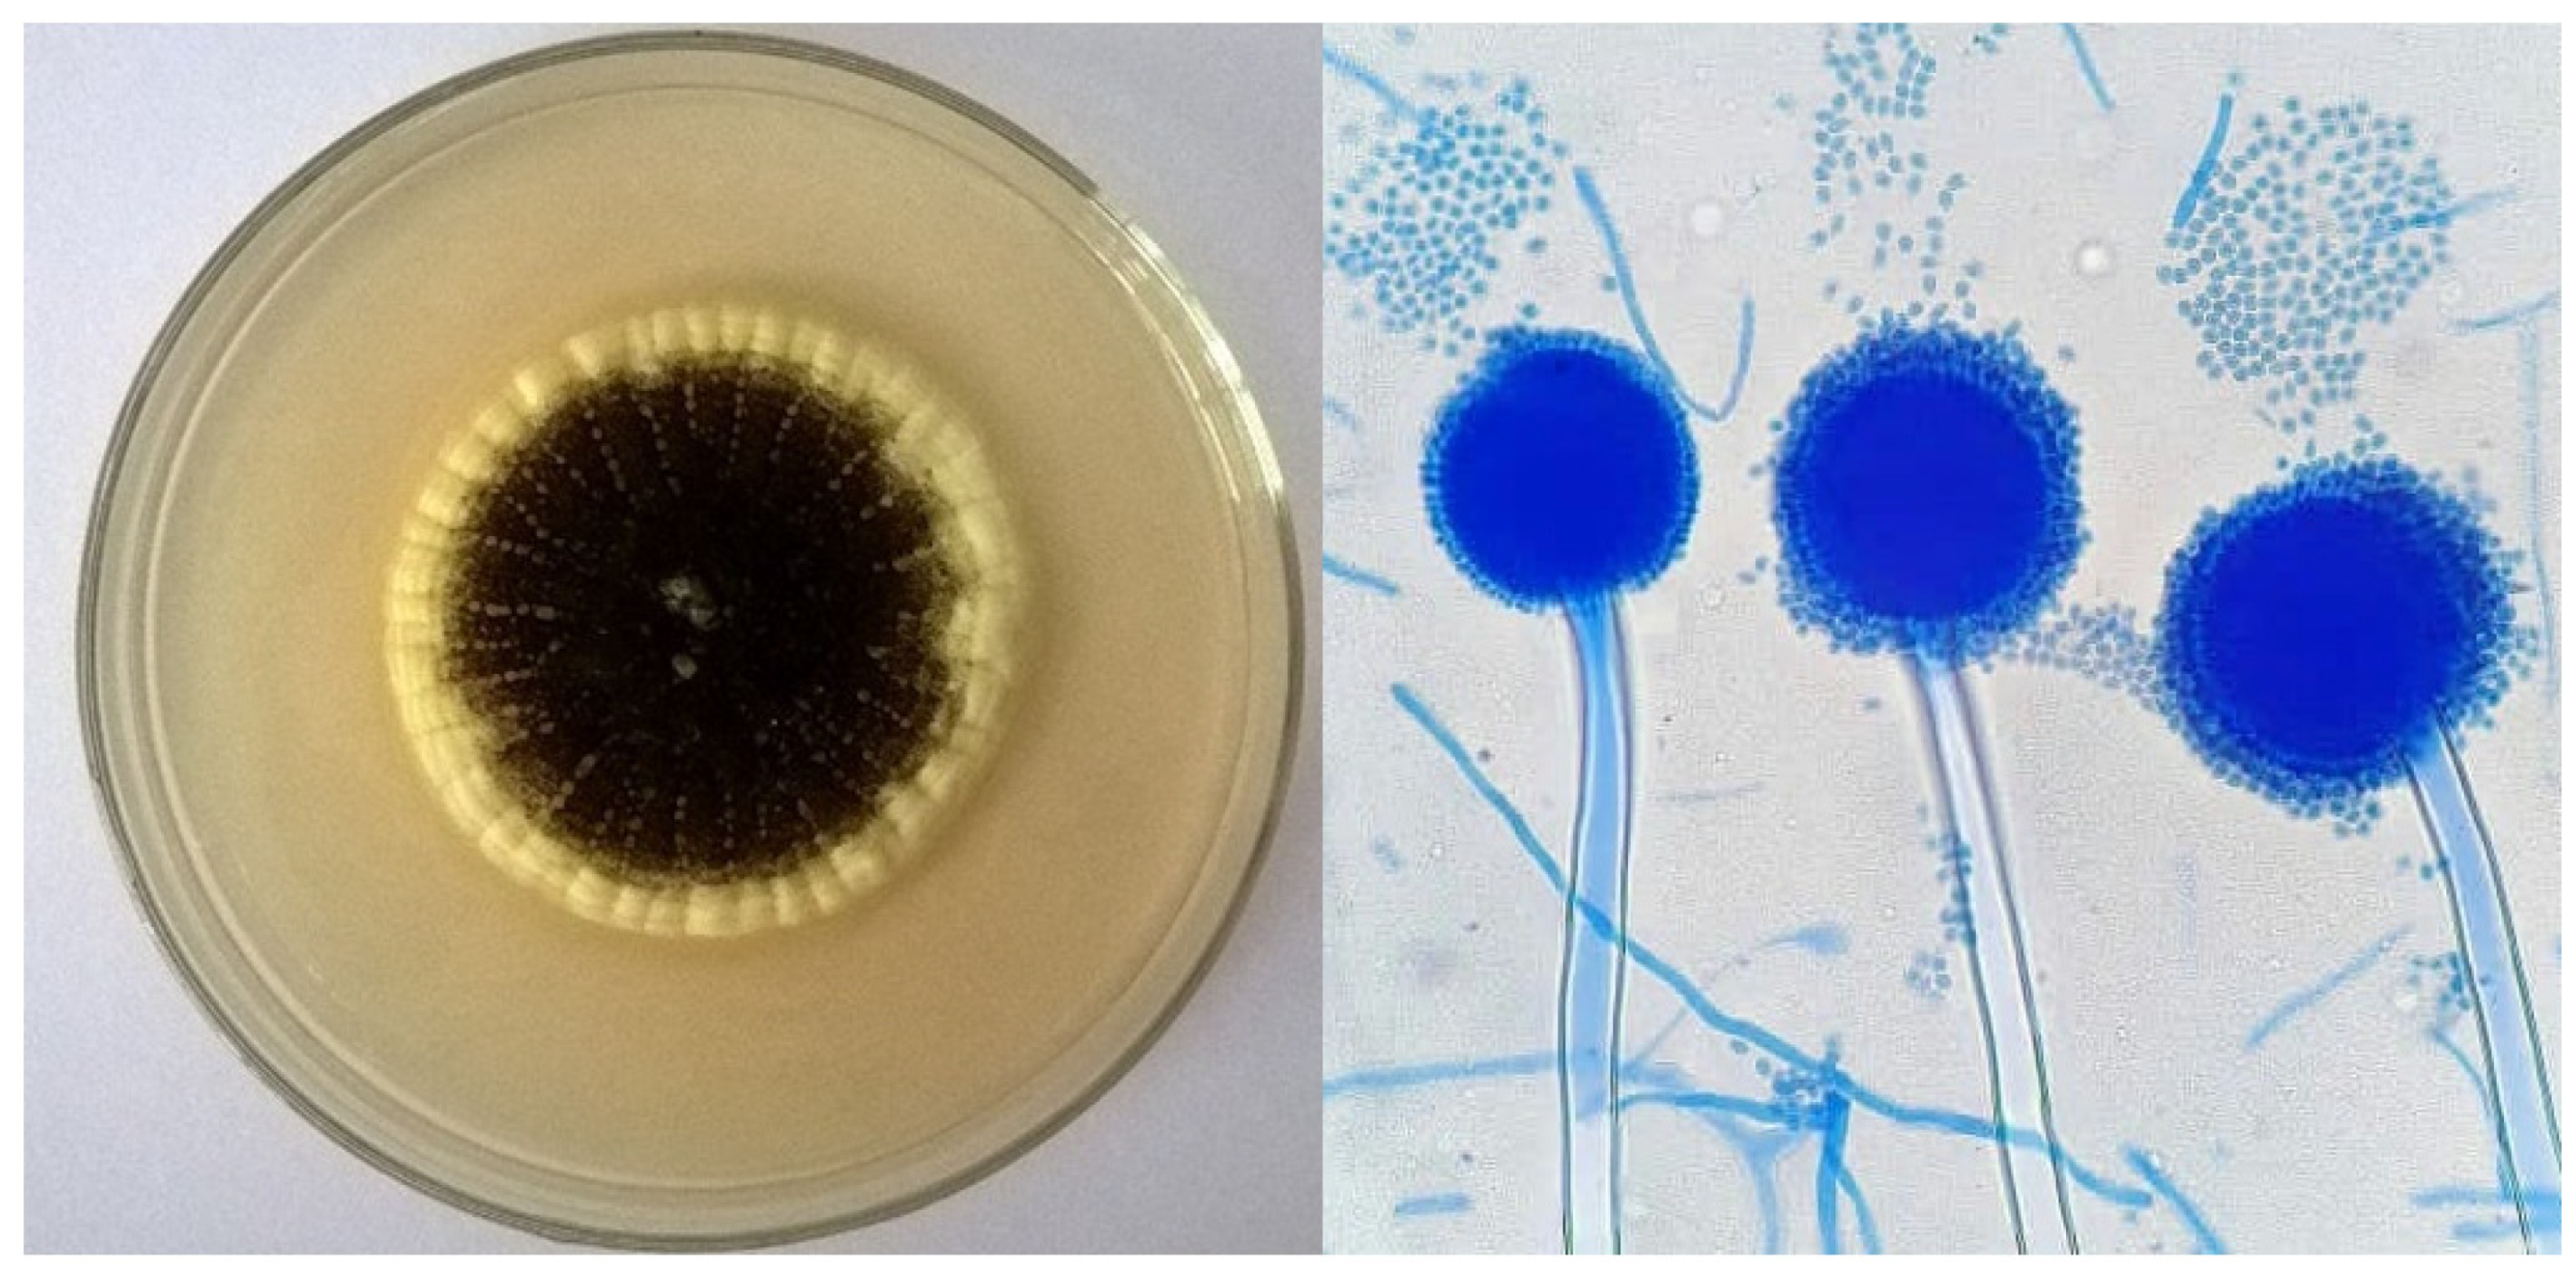
Fermentation 08 00437 g002

Bioconversion of Some Agro-Residues into Organic Acids by Cellulolytic Rock-Phosphate-Solubilizing Aspergillus japonicus
Abstract
1. Introduction
2. Materials and Methods
2.1. Substrates
2.2. Isolation of Fungal Isolates from Sugarcane Bagasse and Faba Bean Straw
2.3. Inoculum Preparation
2.4. Screening of Fungal Isolates
2.5. Cellulase Activity Test
2.6. Rock Phosphate Solubilization Assay
2.7. Detection of the Best Fungal Isolates
2.8. Solid-State Fermentation (SSF)
2.9. Synthesis of Organic Acids
2.10. High-Performance Liquid Chromatography (HPLC)
2.11. Statistical Analysis
3. Results and Discussion
3.1. Identification of Cellulase Production and RP Solubilization by Fungal Isolates
3.2. The Cellulosic Activity of the Isolated Fungi from SCB and FBS
3.3. Rock Phosphate (RP) Solubilization by the Isolated Fungi
3.4. Cellulase Synthesis and RP Solubilization by A. japonicus under SSF Conditions
3.5. Concentrations of RP
3.6. Inoculum Ratio
3.7. Production of Organic Acids
4. Conclusions
Supplementary Materials
Author Contributions
Funding
Institutional Review Board Statement
Informed Consent Statement
Data Availability Statement
Conflicts of Interest
References
- Abou Hussein, S.D.; Sawan, O.M. The utilization of agricultural waste as one of the environmental issues in Egypt (a case study). J. Appl. Sci. Res. 2010, 6, 1116–1124. [Google Scholar]
- Clauser, N.M.; González, G.; Mendieta, C.M.; Kruyeniski, J.; Area, M.C.; Vallejos, M.E. Biomass waste as sustainable raw material for energy and fuels. Sustainability 2021, 13, 794. [Google Scholar] [CrossRef]
- Ganguly, P.; Khan, A.; Das, P.; Bhowal, A. Cellulose from lignocellulose kitchen waste and its application for energy and environment: Bioethanol production and dye removal. Indian Chem. Eng. 2021, 63, 161–171. [Google Scholar] [CrossRef]
- Maki, M.; Leung, K.T.; Qin, W. The prospects of cellulase-producing bacteria for the bioconversion of lignocellulosic biomass. Int. J. Biol. Sci. 2009, 5, 500–516. [Google Scholar] [CrossRef] [PubMed]
- Dashtban, M.; Schraft, H.; Qin, W. Fungal bioconversion of lignocellulosic residues; opportunities & perspectives. Int. J. Biol. Sci. 2009, 5, 578–595. [Google Scholar]
- Jin, X.; Chen, X.; Shi, C.; Li, M.; Guan, Y.; Yu, C.Y.; Yamada, T.; Sacks, E.J.; Peng, J. Determination of hemicellulose, cellulose and lignin content using visible and near infrared spectroscopy in Miscanthus sinensis. Bioresour. Technol. 2017, 241, 603–609. [Google Scholar] [CrossRef]
- Xiao, C.; Tingting, L.; Guang, X.; Ruan, C. Characteristics and mechanisms of biosolubilization of rock phosphate by Aspergillus japonicus. Braz. Arch. Biol. Technol. 2017, 60, e16160541. [Google Scholar] [CrossRef]
- Nasr, S.H.; Mousa, A.M.; Marzouk, M.A.; Yasser, M.M. Quantitative and qualitative analysis of organic acids produced by phosphate solubilizing fungi. Egypt. J. Bot. 2021, 61, 167–176. [Google Scholar] [CrossRef]
- Atallah, O.; Yassin, S. Aspergillus spp. eliminate Sclerotinia sclerotiorum by imbalancing the ambient oxalic acid concentration and parasitizing its sclerotia. Environ. Microbiol. 2020, 22, 5265–5279. [Google Scholar] [CrossRef]
- Li, C.; Huang, C.; Zhao, Y.; Zheng, C.; Su, H.; Zhang, L.; Luo, W.; Zhao, H.; Wang, S.; Huang, L.-J. Effect of choline-based deep eutectic solvent pretreatment on the structure of cellulose and lignin in Bagasse. Processes 2021, 9, 384. [Google Scholar] [CrossRef]
- Irfan, M.; Riaz, M.; Arif, M.S.; Shahzad, S.M.; Saleem, F.; van den Berg, L.; Abbas, F. Estimation and characterization of gaseous pollutant emissions from agricultural crop residue combustion in industrial and household sectors of Pakistan. Atmos. Environ. 2014, 84, 189–197. [Google Scholar] [CrossRef]
- Liska, A.J.; Yang, H.; Milner, M.; Goddard, S.; Blanco-Canqui, H.; Pelton, M.P.; Fang, X.X.; Zhu, H.; Suyker, A.E. Biofuels from crop residue can reduce soil carbon and increase CO2 emissions. Nat. Clim. Change 2014, 4, 398–401. [Google Scholar] [CrossRef]
- Venkatramanan, V.; Shah, S.; Rai, A.K.; Prasad, R. Nexus between crop residue burning, bioeconomy and sustainable development goals over North-Western India. Front. Energy Res. 2021, 8, 614212. [Google Scholar] [CrossRef]
- Chavan, S.; Yadav, B.; Atmakuri, A.; Tyagi, R.; Wong, J.W.; Drogui, P. Bioconversion of organic wastes into value-added products: A review. Bioresour. Technol. 2022, 344, 126398. [Google Scholar] [CrossRef] [PubMed]
- García-Torreiro, M.; López-Abelairas, M.; Lu-Chau, T.; Lema, J. Fungal pretreatment of agricultural residues for bioethanol production. Ind. Crops Prod. 2016, 89, 486–492. [Google Scholar] [CrossRef]
- Zoghlami, A.; Paës, G. Lignocellulosic biomass: Understanding recalcitrance and predicting hydrolysis. Front. Chem. 2019, 7, 874. [Google Scholar] [CrossRef]
- Pagliaro, P.; Femminò, S.; Penna, C. Redox aspects of myocardial ischemia/reperfusion injury and cardio protection. In Oxidative Stress in Heart Diseases; Springer: Singapore, 2019; pp. 289–324. [Google Scholar]
- Dadwal, A.; Sharma, S.; Satyanarayana, T. Progress in ameliorating beneficial characteristics of microbial cellulases by genetic engineering approaches for cellulose saccharification. Front. Microbiol. 2020, 11, 1387. [Google Scholar] [CrossRef]
- Zhao, C.; Chu, Y.; Li, Y.; Yang, C.; Chen, Y.; Wang, X.; Liu, B. High-throughput pyrosequencing used for the discovery of a novel cellulase from a thermophilic cellulose-degrading microbial consortium. Biotechnol. Lett. 2017, 39, 123–131. [Google Scholar] [CrossRef]
- Gao, J.; Weng, H.; Zhu, D.; Yuan, M.; Guan, F.; Xi, Y. Production and characterization of cellulolytic enzymes from the thermoacidophilic fungal Aspergillus terreus M11 under solid-state cultivation of corn stover. Bioresour. Technol. 2008, 99, 7623–7629. [Google Scholar] [CrossRef]
- Singh, R.K.; Patil, T.; Verma, A.; Tekade, S.P.; Sawarkar, A.N. Insights into kinetics, reaction mechanism, and thermodynamic analysis of pyrolysis of rice straw from rice bowl of India. Bioresour. Technol. Rep. 2021, 13, 100639. [Google Scholar] [CrossRef]
- Zhou, J.; Wang, Y.-H.; Chu, J.; Zhuang, Y.-P.; Zhang, S.-L.; Yin, P. Identification and purification of the main components of cellulases from a mutant strain of Trichoderma viride T 100-14. Bioresour. Technol. 2008, 99, 6826–6833. [Google Scholar] [CrossRef]
- Wang, Y.; Guo, Y.; Cao, W.; Liu, H. Synergistic effects on itaconic acid production in engineered Aspergillus niger expressing the two distinct biosynthesis clusters from Aspergillus terreus and Ustilago maydis. Microb. Cell Fact. 2022, 21, 158. [Google Scholar] [CrossRef] [PubMed]
- Njokweni, S.G.; Steyn, A.; Botes, M.; Viljoen-Bloom, M.; van Zyl, W.H. Potential valorization of organic waste streams to valuable organic acids through microbial conversion: A South African case study. Catalysts 2021, 11, 964. [Google Scholar] [CrossRef]
- Asgher, M.; Asad, M.; Legge, R. Enhanced lignin peroxidase synthesis by Phanerochaete chrysosporium in solid state bioprocessing of a lignocellulosic substrate. World J. Microbiol. Biotechnol. 2006, 22, 449–453. [Google Scholar] [CrossRef]
- Kumar, V.; Ahluwalia, V.; Saran, S.; Kumar, J.; Patel, A.K.; Singhania, R.R. Recent developments on solid-state fermentation for production of microbial secondary metabolites: Challenges and solutions. Bioresour. Technol. 2021, 323, 124566. [Google Scholar] [CrossRef]
- Florencio, C.; Cunha, F.M.; Badino, A.C.; Farinas, C.S.; Ximenes, E.; Ladisch, M.R. Secretome analysis of Trichoderma reesei and Aspergillus niger cultivated by submerged and sequential fermentation processes: Enzyme production for sugarcane bagasse hydrolysis. Enzyme Microb. Technol. 2016, 90, 53–60. [Google Scholar] [CrossRef]
- Tse, T.J.; Wiens, D.J.; Reaney, M.J.T. Production of bioethanol—A review of factors affecting ethanol yield. Fermentation 2021, 7, 268. [Google Scholar] [CrossRef]
- Abdel-Shafy, H.I.; Mansour, M.S. Solid waste issue: Sources, composition, disposal, recycling, and valorization. Egypt. J. Pet. 2018, 27, 1275–1290. [Google Scholar] [CrossRef]
- Barbosa, M.A.G.; Rehn, K.G.; Menezes, M.; Mariano, R.D.L.R. Antagonism of Trichoderma species on Cladosporium herbarum and their enzimatic characterization. Braz. J. Microbiol. 2001, 32, 98–104. [Google Scholar] [CrossRef]
- Abo-State, M.A.; Shanab, S.M.; Ali, H.E.; Abdullah, M.A. Screening of antimicrobial activity of selected Egyptian cyanobacterial species. J. Ecol. Heal. Environ. 2015, 3, 7–13. [Google Scholar]
- Narasimha, G.; Sridevi, A.; Buddolla, V.; Subhosh, C.M.; Rajasekhar, R.B. Nutrient effects on production of cellulolytic enzymes by Aspergillus niger. Afr. J. Biotechnol. 2006, 5, 472–476. [Google Scholar]
- Ghose, T. Measurement of cellulase activities. Pure Appl. Chem. 1987, 59, 257–268. [Google Scholar] [CrossRef]
- Miller, G.L. Use of dinitrosalicylic acid reagent for determination of reducing sugar. Anal. Chem. 1959, 31, 426–428. [Google Scholar] [CrossRef]
- Nautiyal, C.S. An efficient microbiological growth medium for screening phosphate solubilizing microorganisms. FEMS Microbiol. Lett. 1999, 170, 265–270. [Google Scholar] [CrossRef]
- Cerezine, P.C.; Nahas, E.; Banzatto, D.A. Soluble phosphate accumulation by Aspergillus niger from fluorapatite. Appl. Microbiol. Biotechnol. 1988, 29, 501–505. [Google Scholar] [CrossRef]
- El-Sawah, M.M.A.; El-Rafey, H.H.; Saber, W.I.A. Reduction of phytic acid content in soy bean by A. niger phytase immobilized into gelatin film by cross-linking. J. Agric. Sci. Mansoura Univ. 2001, 26, 5165–5175. [Google Scholar]
- Bonneville, S.; Delpomdor, F.; Préat, A.; Chevalier, C.; Araki, T.; Kazemian, M.; Steele, A.; Schreiber, A.; Wirth, R.; Benning, L.G. Molecular identification of fungi microfossils in a Neoproterozoic shale rock. Sci. Adv. 2020, 6, eaax7599. [Google Scholar] [CrossRef]
- Ramirez, C. Manual and Atlas of the Penicillia; Elsevier Biomedical Press: Amsterdam, The Netherlands; New York, NY, USA; Sole Distributors for the USA and Canada, Elsevier/North-Holland: New York, NY, USA, 1982. [Google Scholar]
- Raper, K.B.; Fennell, D.I. The Genus Aspergillus; Williams and Wilkins: Philadelphia, PA, USA, 1965. [Google Scholar]
- Watanabe, T. Pictorial Atlas of Soil and Seed Fungi: Morphologies of Cultured Fungi and Key to Species; CRC Press: Boca Raton, FL, USA, 2002. [Google Scholar]
- Minamisawa, K.; Seki, T.; Onodera, S.; Kubota, M.; Asami, T. Genetic relatedness of Bradyrhizobium japonicum field isolates as revealed by repeated sequences and various other characteristics. Appl. Environ. Microbiol. 1992, 58, 2832–2839. [Google Scholar] [CrossRef]
- Xu, C.; Long, M.; Wu, X.; Xu, H.; Chen, Z.; Zhang, F.; Xu, L. Screening and characterization of the high-cellulase-producing strain Aspergillus glaucus XC9. Front. Biol. China 2006, 1, 35–40. [Google Scholar] [CrossRef]
- Belal, E.B.; El-Mahrouk, M. Solid-state fermentation of rice straw residues for its use as growing medium in ornamental nurseries. Acta Astronaut. 2010, 67, 1081–1089. [Google Scholar] [CrossRef]
- Chen, Y. Effects of aging-acceleration by electric field on free amino acid of claret. Liquor Making Sci. Technol. 2004, 6, 80–81. [Google Scholar]
- Samson, R.A.; Houbraken, J. Phylogenetic and Taxonomic Studies on the Genera Penicillium and Talaromyces; CBS-KNAW Fungal Biodiversity Centre: Utrecht, The Netherlands, 2011. [Google Scholar]
- Khalil, M.A.A.; Hashem, H.A. Morphological changes of conidiogenesis in two Aspergillus species. J. Pure Appl. Microbiol. 2018, 12, 2041–2048. [Google Scholar] [CrossRef]
- Gams, W.; Christensen, M.; Onions, A.H.; Pitt, J.I.; Samson, R.A. Infrageneric taxa of Aspergillus. In Advances in Penicillium and Aspergillus Systematics; Springer: Berlin/Heidelberg, Germany, 1986; pp. 55–62. [Google Scholar]
- Yang, L.; Lübeck, M.; Lübeck, P. Aspergillus as a versatile cell factory for organic acid production. Fungal Biol. Rev. 2017, 31, 33–49. [Google Scholar] [CrossRef]
- Bansal, N.; Soni, R.; Janveja, C.; Soni, S.K. Production of xylanase-cellulase complex by Bacillus subtilis NS7 for the biodegradation of agro-waste residues. Lignocellulose 2012, 1, 196–209. [Google Scholar]
- Dhillon, G.S.; Oberoi, H.S.; Kaur, S.; Bansal, S.; Brar, S.K. Value-addition of agricultural wastes for augmented cellulase and xylanase production through solid-state tray fermentation employing mixed-culture of fungi. Ind. Crops Prod. 2011, 34, 1160–1167. [Google Scholar] [CrossRef]
- Liu, J.; Ørskov, E. Cellulase treatment of untreated and steam pre-treated rice straw—Effect on in vitro fermentation characteristics. Anim. Feed Sci. Technol. 2000, 88, 189–200. [Google Scholar] [CrossRef]
- Badhan, A.; Chadha, B.; Kaur, J.; Saini, H.; Bhat, M. Production of multiple xylanolytic and cellulolytic enzymes by thermophilic fungus Myceliophthora sp. IMI 387099. Bioresour. Technol. 2007, 98, 504–510. [Google Scholar] [CrossRef]
- Saber, W.; El-Naggar, N.E.; AbdAl-Aziz, S. Bioconversion of lignocellulosic wastes into organic acids by cellulolytic rock phosphate-solubilizing fungal isolates grown under solid-state fermentation conditions. Res. J. Microbiol. 2010, 5, 1–20. [Google Scholar] [CrossRef]
- El-Nahrawy, S.; Metwally, M.; El-Kodoos, A.; Rizk, Y.; Belal, E.-S.B.; Shabana, S.A.; El-Refai, I.M. Optimization of culture conditions for production of cellulase by Aspergillus tubingensis KY615746 using rice straw waste. Environ. Biodivers. Soil Secur. 2017, 1, 177–189. [Google Scholar]
- Narsale, P.V.; Patel, S.R.; Acharya, P. Role of Aspergillus flavus on biodegradation of lignocellulosic waste millet straw and optimization parameters for enzyme hydrolysis and ethanol production under solid state fermentation. Int. J. Curr. Microbiol. Appl. Sci. 2018, 7, 429–445. [Google Scholar] [CrossRef]
- Adour, L.; Couriol, C.; Amrane, A.; Prigent, Y. Growth of Geotrichum candidum and Penicillium camembertii in liquid media in relation with the consumption of carbon and nitrogen sources and the release of ammonia and carbon dioxide. Enzyme Microb. Technol. 2002, 31, 533–542. [Google Scholar] [CrossRef]
- Dutta, D.; Das, M.D. Effect of C/N ratio and microelements on nutrient dynamics and cell morphology in submerged fermentation of Aspergillus giganteus MTCC 8408 using Taguchi DOE. 3 Biotech 2017, 7, 34. [Google Scholar] [CrossRef] [PubMed][Green Version]
- Youssef, M. Organic Acids Associated with the Fungal Degradation of Rice Straw; MSc. (Microbiology) Botany Department, Faculty of Science, Mansoura University: Mansoura, Egypt, 2016. [Google Scholar]
- Ikram-Ul-Haq, U.H.; Shahzadi, K.; Javed, M.; Qadeer, M. Cotton Saccharifying activity of cellulases by Trichoderma harzianum UM-11 in shake flask. J. Bot. 2005, 1, 19–22. [Google Scholar]
- Andersson, R.; Hedlund, B. HPLC analysis of organic acids in lactic acid fermented vegetables. Z. Lebensm. Unters Forsch. 1983, 176, 440–443. [Google Scholar] [CrossRef] [PubMed]
- El-Naggar, N.E.-A.; El-Hersh, M.S. Organic acids associated with saccharification of cellulosic wastes during solid-state fermentation. J. Microbiol. 2011, 49, 58–65. [Google Scholar] [CrossRef] [PubMed]
- Saber, W.I.; El-Naggar, N.E.; El-Hersh, M.S.; El-Khateeb, A.Y. An innovative synergism between Aspergillus oryzae and Azotobacter chroococcum for bioconversion of cellulosic biomass into organic acids under restricted nutritional conditions using multi-response surface optimization. Biotechnology 2015, 14, 47–57. [Google Scholar] [CrossRef]
- Kumari, A.; Kapoor, K.; Kundu, B.; Kumari Mehta, R. Identification of organic acids produced during rice straw decomposition and their role in rock phosphate solubilization. Plant Soil Environ. 2008, 54, 72. [Google Scholar] [CrossRef]

| Parameters * | Sugarcane Bagasse | Faba Bean Straw |
|---|---|---|
| Organic carbon (%) | 56.00 ± 0.12 | 44.00 ± 0.34 |
| Total N (%) | 0.70 ± 0.22 | 1.47 ± 0.11 |
| C/N ratio | 80.00 ± 0.14 | 29.93 ± 0.35 |
| Total P (%) | 0.23 ± 0.09 | 0.32 ± 0.07 |
| Total K (%) | 0.79 ± 0.16 | 1.34 ± 0.08 |
| Fungal Isolates | Final Culture pH * | Titratable Acidity (µg NaOH mL−1) * | Soluble P (µg mL−1) * | Phytase (U mL−1) * |
|---|---|---|---|---|
| F1 (Aspergillus spp.) | 5.19 ± 0.23 a | 67.48 ± 0.23 b,c | 24.47 ± 0.43 b,d | 15.10 ± 0.23 a,b |
| F2 (Aspergillus spp.) | 5.76 ± 0.13 a | 74.88 ± 0.22 a,b | 24.03 ± 0.54 c,d | 12.15 ± 0.35 e |
| F3 (Aspergillus spp.) | 5.57 ± 0.15 a | 72.44 ± 0.32 b | 24.95 ± 0.22 b,c | 14.29 ± 0.41 c,d |
| F4 (Aspergillus spp.) | 5.73 ± 0.23 a | 74.54 ± 0.24 a,b | 23.80 ± 0.12 d | 15.29 ± 0.33 c |
| F5 (Aspergillus spp.) | 4.82 ± 0.18 b | 53.82 ± 0.27 d | 29.09 ± 0.15 a | 16.21 ± 0.21 a,b |
| F6 (Aspergillus spp.) | 5.91 ± 0.14 a | 76.88 ± 0.28 a | 22.55 ± 0.17 e | 14.23 ± 0.23 d |
| F7 (Aspergillus spp.) | 5.95 ± 0.14 a | 77.35 ± 0.23 a | 21.11 ± 0.31 e | 14.87 ± 0.11 d |
| F8 (Aspergillus spp.) | 5.31 ± 0.18 a | 69.09 ± 0.25 b | 20.20 ± 0.32 e,f | 14.00 ± 0.23 d |
| F9 (Aspergillus spp.) | 5.79 ± 0.11 a | 75.36 ± 0.24 a | 19.22 ± 0.35 f,g | 14.59 ± 0.28 c |
| F10 (Aspergillus spp.) | 5.20 ± 0.09 a | 67.63 ± 0.34 b,c | 25.29 ± 0.37 c | 15.02 ± 0.37 b,c |
| F11 (Aspergillus spp.) | 4.41 ± 0.17 b | 60.75 ± 0.29 d | 29.97 ± 0.45 a | 16.44 ± 0.55 a |
| F12 (Aspergillus spp.) | 5.573 ± 0.13 a | 72.44 ± 0.30 a,b | 23.68 ± 0.44 c,d | 15.29 ± 0.32 b,c |
| F13 (Aspergillus spp.) | 5.932 ± 0.16 a | 77.11 ± 0.33 a | 24.79 ± 0.12 b | 15.39 ± 0.31 b,c |
| F14 (Aspergillus spp.) | 4.652 ± 0.18 b | 57.33 ± 0.39 e | 29.60 ± 0.23 a | 16.33 ± 0.33 b |
| F15 (Aspergillus spp.) | 4.330 ± 0.16 b | 62.47 ± 0.35 d,e | 30.15 ± 0.13 a | 17.78 ± 0.36 a |
| Treatment | FPase (Unit g−1) * | β-Glucosidase (Unit g−1) * | CMCase (Unit g−1) * | Soluble P (µg g−1) * |
|---|---|---|---|---|
| First week | ||||
| T1 | 22.34 ± 2.2 | 66.02 ± 6.50 | 166.29 ± 11.20 | 60.01 ± 4.30 |
| T2 | 24.39 ± 3.2 | 71.17 ± 5.98 | 159.99 ± 10.12 | 66.07 ± 4.61 |
| T3 | 25.75 ± 2.6 | 75.25 ± 6.01 | 166.97 ± 12.00 | 68.15 ± 4.88 |
| T4 | 30.49 ± 2.9 | 90.47 ± 6.00 | 171.45 ± 13.65 | 70.07 ± 5.09 |
| T5 | 29.30 ± 3.3 | 88.9 ± 5.50 | 167.39 ± 12.87 | 68.12 ± 5.12 |
| T6 | 27.12 ± 2.4 | 80.36 ± 7.02 | 166.56 ± 9.23 | 60.16 ± 5.00 |
| T7 | 26.39 ± 2.1 | 77.17 ± 6.22 | 162.88 ± 9.12 | 67.12 ± 4.89 |
| Second weeks | ||||
| T1 | 26.66 ± 3.2 | 70.46 ± 4.99 | 175.28 ± 13.23 | 67.76 ± 5.34 |
| T2 | 27.71 ± 2.9 | 76.61 ± 5.54 | 169.98 ± 13.00 | 74.82 ± 4.98 |
| T3 | 30.07 ± 2.8 | 80.69 ± 5.69 | 173.96 ± 14.55 | 77.9 ± 4.55 |
| T4 | 34.81 ± 2.0 | 94.91 ± 6.87 | 182.44 ± 13.23 | 79.82 ± 4.87 |
| T5 | 32.62 ± 3.1 | 91.34 ± 6.03 | 177.38 ± 12.89 | 76.87 ± 5.12 |
| T6 | 30.44 ± 2.44 | 85.8 ± 6.69 | 174.55 ± 12.98 | 68.91 ± 5.87 |
| T7 | 29.71 ± 2.9 | 82.61 ± 6.49 | 173.87 ± 14.56 | 73.87 ± 5.14 |
| Third week | ||||
| T1 | 30.56 ± 3.3 | 78.26 ± 5.88 | 189.50 ± 17.87 | 77.64 ± 5.23 |
| T2 | 31.61 ± 3.2 | 82.41 ± 5.90 | 185.20 ± 15.00 | 83.7 ± 5.69 |
| T3 | 32.97 ± 3.1 | 87.49 ± 6.33 | 189.18 ± 16.98 | 84.78 ± 5.45 |
| T4 | 38.71 ± 2.8 | 95.71 ± 6.49 | 198.66 ± 17.00 | 88.7 ± 5.76 |
| T5 | 37.52 ± 2.9 | 94.14 ± 6.54 | 185.6 ± 15.78 | 85.75 ± 5.11 |
| T6 | 36.34 ± 2.6 | 91.6 ± 6.83 | 189.77 ± 17.00 | 77.79 ± 4.87 |
| T7 | 34.61 ± 2.7 | 89.41 ± 6.23 | 183.09 ± 16.98 | 83.75 ± 4.98 |
| Fourth week | ||||
| T1 | 36.44 ± 2.6 | 80.16 ± 5.12 | 213.38 ± 21.76 | 88.77 ± 4.89 |
| T2 | 37.49 ± 2.6 | 86.31 ± 5.29 | 209.08 ± 18.99 | 94.83 ± 5.22 |
| T3 | 39.85 ± 2.1 | 91.39 ± 6.74 | 211.06 ± 17.54 | 96.91 ± 5.29 |
| T4 | 43.59 ± 2.2 | 98.61 ± 7.02 | 212.54 ± 20.34 | 98.83 ± 5.87 |
| T5 | 41.4 ± 2.9 | 97.04 ± 6.69 | 211.48 ± 19.00 | 97.88 ± 5.80 |
| T6 | 40.22 ± 3.0 | 95.5 ± 6.34 | 211.65 ± 18.87 | 88.92 ± 5.66 |
| T7 | 38.49 ± 3.2 | 93.31 ± 5.58 | 208.97 ± 19.89 | 86.88 ± 5.42 |
| Fifth week | ||||
| T1 | 28.67 ± 2.5 | 73.46 ± 5.67 | 177.17 ± 17.89 | 84.22 ± 5.12 |
| T2 | 30.72 ± 2.9 | 81.61 ± 5.79 | 167.87 ± 17.22 | 90.28 ± 5.23 |
| T3 | 31.08 ± 2.8 | 82.69 ± 6.73 | 174.85 ± 18.91 | 92.36 ± 5.98 |
| T4 | 35.82 ± 2.0 | 89.91 ± 6.09 | 181.33 ± 16.16 | 94.28 ± 5.83 |
| T5 | 34.63 ± 2.0 | 86.34 ± 6.71 | 177.27 ± 18.23 | 91.33 ± 5.12 |
| T6 | 33.45 ± 2.1 | 84.8 ± 5.88 | 175.44 ± 17.77 | 83.37 ± 5.82 |
| T7 | 33.72 ± 2.7 | 83.61 ± 5.74 | 174.76 ± 18.26 | 90.33 ± 5.48 |
| Treatment | FPase (Unit g−1) * | β-Glucosidase (Unit g−1) * | CMCase (Unit g−1) * | Soluble P (µg g−1) * |
|---|---|---|---|---|
| 25 mg P2O5 | ||||
| T1 | 25.04 ± 2.0 | 69.12 ± 5.40 | 176.49 ± 8.20 | 62.00 ± 3.40 |
| T2 | 26.69 ± 2.2 | 74.37 ± 4.78 | 189.90 ± 9.02 | 66.77 ± 3.91 |
| T3 | 26.15 ± 2.4 | 79.55 ± 5.09 | 199.47 ± 12.00 | 67.10 ± 4.18 |
| T4 | 43.09 ± 1.6 | 93.17 ± 4.20 | 221.15 ± 10.05 | 72.54 ± 4.09 |
| T5 | 39.10 ± 2.3 | 89.98 ± 4.40 | 197.99 ± 10.80 | 69.22 ± 5.42 |
| T6 | 36.22 ± 2.9 | 86.76 ± 5.22 | 191.26 ± 9.93 | 62.76 ± 4.87 |
| T7 | 32.49 ± 1.8 | 83.97 ± 4.72 | 182.18 ± 8.52 | 68.10 ± 4.93 |
| 50 mg P2O5 | ||||
| T1 | 28.60 ± 2.22 | 73.41 ± 3.19 | 198.20 ± 8.03 | 77.60 ± 5.39 |
| T2 | 29.11 ± 2.91 | 77.41 ± 4.24 | 202.88 ± 8.29 | 79.44 ± 5.33 |
| T3 | 36.00 ± 2.63 | 86.09 ± 4.39 | 218.90 ± 9.05 | 83.09 ± 5.15 |
| T4 | 42.44 ± 2.44 | 98.71 ± 4.80 | 249.64 ± 9.13 | 94.42 ± 5.77 |
| T5 | 37.43 ± 2.11 | 90.30 ± 4.83 | 240.28 ± 9.29 | 92.80 ± 5.00 |
| T6 | 33.49 ± 2.15 | 89.22 ± 4.79 | 227.05 ± 8.48 | 88.11 ± 5.08 |
| T7 | 31.27 ± 2.72 | 89.49 ± 5.09 | 210.17 ± 8.96 | 81.27 ± 4.98 |
| 75 mg P2O5 | ||||
| T1 | 34.28 ± 3.23 | 82.26 ± 6.07 | 199.71 ± 11.43 | 85.44 ± 6.22 |
| T2 | 35.04 ± 3.21 | 85.41 ± 7.20 | 208.00 ± 11.29 | 88.51 ± 6.61 |
| T3 | 39.69 ± 3.11 | 88.49 ± 7.73 | 248.10 ± 11.76 | 101.70 ± 6.35 |
| T4 | 48.18 ± 2.80 | 103.71 ± 7.41 | 267.61 ± 12.33 | 116.76 ± 6.06 |
| T5 | 45.34 ± 2.66 | 96.14 ± 7.54 | 251.80 ± 11.18 | 109.85 ± 6.21 |
| T6 | 42.68 ± 2.82 | 96.6 ± 7.03 | 249.77 ± 11.30 | 103.59 ± 6.57 |
| T7 | 37.42 ± 2.59 | 93.41 ± 7.13 | 231.19 ± 10.18 | 96.15 ± 6.78 |
| 100 mg P2O5 | ||||
| T1 | 31.72 ± 2.6 | 74.67 ± 6.66 | 190.54 ± 7.23 | 80.12 ± 6.02 |
| T2 | 32.13 ± 2.6 | 81.88 ± 6.12 | 193.18 ± 7.19 | 82.60 ± 6.91 |
| T3 | 35.67 ± 2.1 | 82.12 ± 6.48 | 198.08 ± 7.76 | 91.38 ± 6.65 |
| T4 | 38.38 ± 2.2 | 87.75 ± 6.74 | 217.43 ± 7.18 | 96.84 ± 6.36 |
| T5 | 35.74 ± 2.9 | 83.38 ± 6.86 | 211.53 ± 7.79 | 90.72 ± 6.01 |
| T6 | 31.10 ± 3.0 | 80.80 ± 6.45 | 209.62 ± 7.22 | 88.44 ± 6.27 |
| T7 | 28.66 ± 3.2 | 79.05 ± 6.24 | 201.06 ± 7.05 | 81.08 ± 6.08 |
| Treatment | FPase (Unit g−1) * | β-Glucosidase (Unit g−1) * | CMCase (Unit g−1) * | Soluble P (µg g−1) * |
|---|---|---|---|---|
| 2.5% (v/w) | ||||
| T1 | 33.14 ± 2.5 | 76.01 ± 4.10 | 196.21 ± 6.27 | 69.11 ± 4.00 |
| T2 | 35.29 ± 3.4 | 81.19 ± 4.88 | 202.00 ± 6.02 | 71.87 ± 4.01 |
| T3 | 35.78 ± 2.4 | 79.39 ± 4.11 | 230.94 ± 6.10 | 73.75 ± 4.00 |
| T4 | 43.33 ± 2.4 | 83.02 ± 4.30 | 244.41 ± 7.75 | 81.17 ± 4.19 |
| T5 | 39.22 ± 3.0 | 80.91 ± 4.70 | 222.30 ± 7.07 | 80.22 ± 4.02 |
| T6 | 32.10 ± 2.1 | 71.56 ± 4.42 | 194.53 ± 7.33 | 79.16 ± 4.20 |
| T7 | 29.30 ± 2.0 | 70.07 ± 4.12 | 191.80 ± 7.02 | 72.02 ± 4.69 |
| 5% (v/w) | ||||
| T1 | 36.56 ± 2.18 | 72.06 ± 4.09 | 265.38 ± 7.03 | 82.44 ± 4.24 |
| T2 | 37.81 ± 2.23 | 79.21 ± 4.14 | 279.08 ± 7.10 | 87.80 ± 4.78 |
| T3 | 40.27 ± 2.45 | 83.19 ± 4.59 | 290.66 ± 8.35 | 91.77 ± 4.55 |
| T4 | 46.01 ± 2.00 | 95.01 ± 4.47 | 301.24 ± 8.20 | 99.02 ± 4.37 |
| T5 | 45.22 ± 2.11 | 92.30 ± 4.23 | 279.08 ± 8.09 | 96.67 ± 4.02 |
| T6 | 42.04 ± 2.40 | 88.81 ± 4.19 | 274.35 ± 7.18 | 88.01 ± 4.17 |
| T7 | 38.11 ± 2.44 | 82.01 ± 4.09 | 263.17 ± 7.16 | 81.97 ± 4.04 |
| 7.5% (v/w) | ||||
| T1 | 41.36 ± 3.0 | 90.20 ± 5.08 | 291.55 ± 8.41 | 99.69 ± 4.20 |
| T2 | 44.11 ± 3.1 | 92.11 ± 5.40 | 302.21 ± 8.50 | 101.74 ±4.89 |
| T3 | 46.57 ± 3.0 | 97.09 ± 5.03 | 302.38 ± 8.18 | 109.38 ± 4.55 |
| T4 | 51.41 ± 2.3 | 98.31 ± 5.29 | 322.60 ± 8.40 | 114.22 ± 4.46 |
| T5 | 47.32 ± 2.2 | 92.12 ± 5.14 | 308.20 ± 8.28 | 101.25 ± 4.21 |
| T6 | 45.30 ± 2.2 | 90.11 ± 5.33 | 291.17 ± 8.20 | 94.09 ± 4.47 |
| T7 | 43.60 ± 2.1 | 89.11 ± 5.13 | 279.29 ± 8.18 | 89.15 ± 4.28 |
| 10% (v/w) | ||||
| T1 | 39.46 ± 2.22 | 78.11 ± 4.72 | 281.68 ± 7.06 | 87.43 ± 4.19 |
| T2 | 42.43 ± 2.43 | 81.21 ± 4.69 | 288.48 ± 7.19 | 92.62 ± 4.02 |
| T3 | 43.81 ± 2.28 | 86.09 ± 4.44 | 291.26 ± 7.24 | 95.55 ± 4.19 |
| T4 | 47.50 ± 2.41 | 90.31 ± 4.12 | 302.44 ± 7.30 | 99.21 ± 4.37 |
| T5 | 40.45 ± 2.53 | 90.00 ± 4.39 | 291.38 ± 7.03 | 95.42 ± 4.20 |
| T6 | 40.52 ± 2.05 | 82.54 ± 4.14 | 281.25 ± 7.80 | 87.21 ± 4.46 |
| T7 | 36.49 ± 2.12 | 75.11 ± 4.08 | 281.37 ± 7.80 | 84.11 ± 4.12 |
Publisher’s Note: MDPI stays neutral with regard to jurisdictional claims in published maps and institutional affiliations. |
© 2022 by the authors. Licensee MDPI, Basel, Switzerland. This article is an open access article distributed under the terms and conditions of the Creative Commons Attribution (CC BY) license (https://creativecommons.org/licenses/by/4.0/).
Share and Cite
Mahgoub, S.A.; Kedra, E.G.A.; Abdelfattah, H.I.; Abdelbasit, H.M.; Alamoudi, S.A.; Al-Quwaie, D.A.; Selim, S.; Alsharari, S.S.; Saber, W.I.A.; El-Mekkawy, R.M. Bioconversion of Some Agro-Residues into Organic Acids by Cellulolytic Rock-Phosphate-Solubilizing Aspergillus japonicus. Fermentation 2022, 8, 437. https://doi.org/10.3390/fermentation8090437
Mahgoub SA, Kedra EGA, Abdelfattah HI, Abdelbasit HM, Alamoudi SA, Al-Quwaie DA, Selim S, Alsharari SS, Saber WIA, El-Mekkawy RM. Bioconversion of Some Agro-Residues into Organic Acids by Cellulolytic Rock-Phosphate-Solubilizing Aspergillus japonicus. Fermentation. 2022; 8(9):437. https://doi.org/10.3390/fermentation8090437
Chicago/Turabian StyleMahgoub, Samir A., Elmadawy G. A. Kedra, Hassan I. Abdelfattah, Howaida M. Abdelbasit, Soha A. Alamoudi, Diana A. Al-Quwaie, Samy Selim, Salam S. Alsharari, Wesam I. A. Saber, and Rasha M. El-Mekkawy. 2022. "Bioconversion of Some Agro-Residues into Organic Acids by Cellulolytic Rock-Phosphate-Solubilizing Aspergillus japonicus" Fermentation 8, no. 9: 437. https://doi.org/10.3390/fermentation8090437
APA StyleMahgoub, S. A., Kedra, E. G. A., Abdelfattah, H. I., Abdelbasit, H. M., Alamoudi, S. A., Al-Quwaie, D. A., Selim, S., Alsharari, S. S., Saber, W. I. A., & El-Mekkawy, R. M. (2022). Bioconversion of Some Agro-Residues into Organic Acids by Cellulolytic Rock-Phosphate-Solubilizing Aspergillus japonicus. Fermentation, 8(9), 437. https://doi.org/10.3390/fermentation8090437

